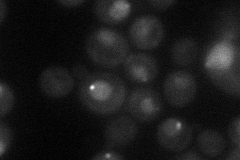
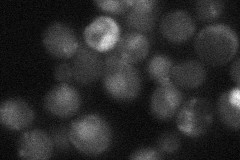
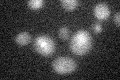

View description
Polo-like kinase with similarity to Xenopus Plx1 and S. pombe Plo1p; found at bud neck, nucleus and SPBs; has multiple functions in mitosis and cytokinesis through phosphorylation of substrates; may be a Cdc28p substrate
Localization:
Intensity:
Fold change:
Significance:
-
C’ GFP library in SD

below threshold15.48 -
N' NOP1pr-GFP in SD
punctate,nucleus31.5232 -
N' TEF2pr-mCherry in SD

nucleus7.04198 -
N' NATIVEpr-GFP in SD
punctate,nucleus29.0498 -
N' TEF2pr-VC and Cyto-VN in SD

below threshold25.3522 -
C’ GFP library in SD+DTT

cytosol17.371.12No -
C’ GFP library in SD+H2O2

cytosol19.461.25No -
C’ GFP library in Starvation Media
cytosol16.571.06No -
C’ GFP library on the background of Pup2-DaMP

below threshold -
C’ GFP library on the background of CCT mutant

below threshold17.84281.1519No
